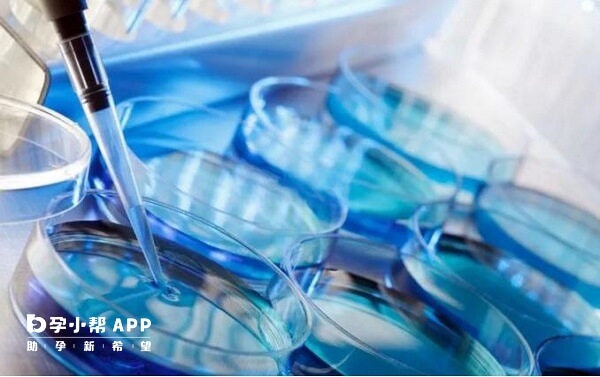
注射手法操作不当可能会造成美诺孕的污染

在试管促排中,美诺孕通常采用皮下注射,一般选择腹部或大腿外侧等部位,不过因个体差异较大,所以具体的注射剂量是多少并不能一概而论。若卵巢反应良好,可能从75IU/天开始使用,而随着卵泡生长,医生可能会让患者增加至150IU/天,以促进卵泡进一步发育,但具体用药期间应以实际为准。

试管婴儿促排卵中常用注射液美诺孕的使用,一般都是女性在家自行完成的注射。对于刚接触这类药物的女性来说,可能不大会用,那么本文就美诺孕的用法用量,以及注射方法和部位进行了详细讲解,不清楚的姐妹可以看看。
1、用于助孕技术
一般在女性月经的第3-5天开始注射,每次75-150U的用量,一天一次,连续注射七天,与此同时需要B超配合监测。当卵泡即将成熟之际,开始注射HCG诱导最终排卵。如果没有顺利怀孕,可以再继续该治疗反复2个周期。
2、治疗闭经或下丘脑—垂体无排卵性不孕
大多数都是等克罗米芬或者溴隐亭诱导女性排卵没有效果的时候,再合并使用美诺孕以及绒促性素,用法用量与助孕技术上一致。

3、治疗少精症(促性腺激素低下导致)
在使用绒促形素让睾丸体积变大到8ml左右的时候,一周注射一次美诺孕就可以了,一次75-150U的量。
美诺孕属于激素生育剂类的药物,通过模仿体内天然存在的激素,通过注射的方法外源性给予激素,有利于胚胎着床还有之后的发育,最重要的作用就是促进排卵还有妊娠。
1、准备好所有物品
首先把所需物品准备好即注射器、酒精棉片、无菌纱布等,在使用之前要检查稀释液是否澄清无色,如果浑浊有颗粒不得使用。
2、抽取药液
用拇指将药粉药瓶还有稀释液药瓶的塑料保护盖揭开,然后用酒精棉片轻轻擦拭药瓶顶部,去除注射器和针头。先不要着急取出针头,然后把药瓶倒转,再回拉柱塞。
等把瓶中所有药液都抽吸到注射器当中后,把针头还有注射器从药瓶中抽出然后再盖上配药针头的针帽,把针头从注射器上旋转下来。要注意手法,避免不当操作,污染针头和药物。